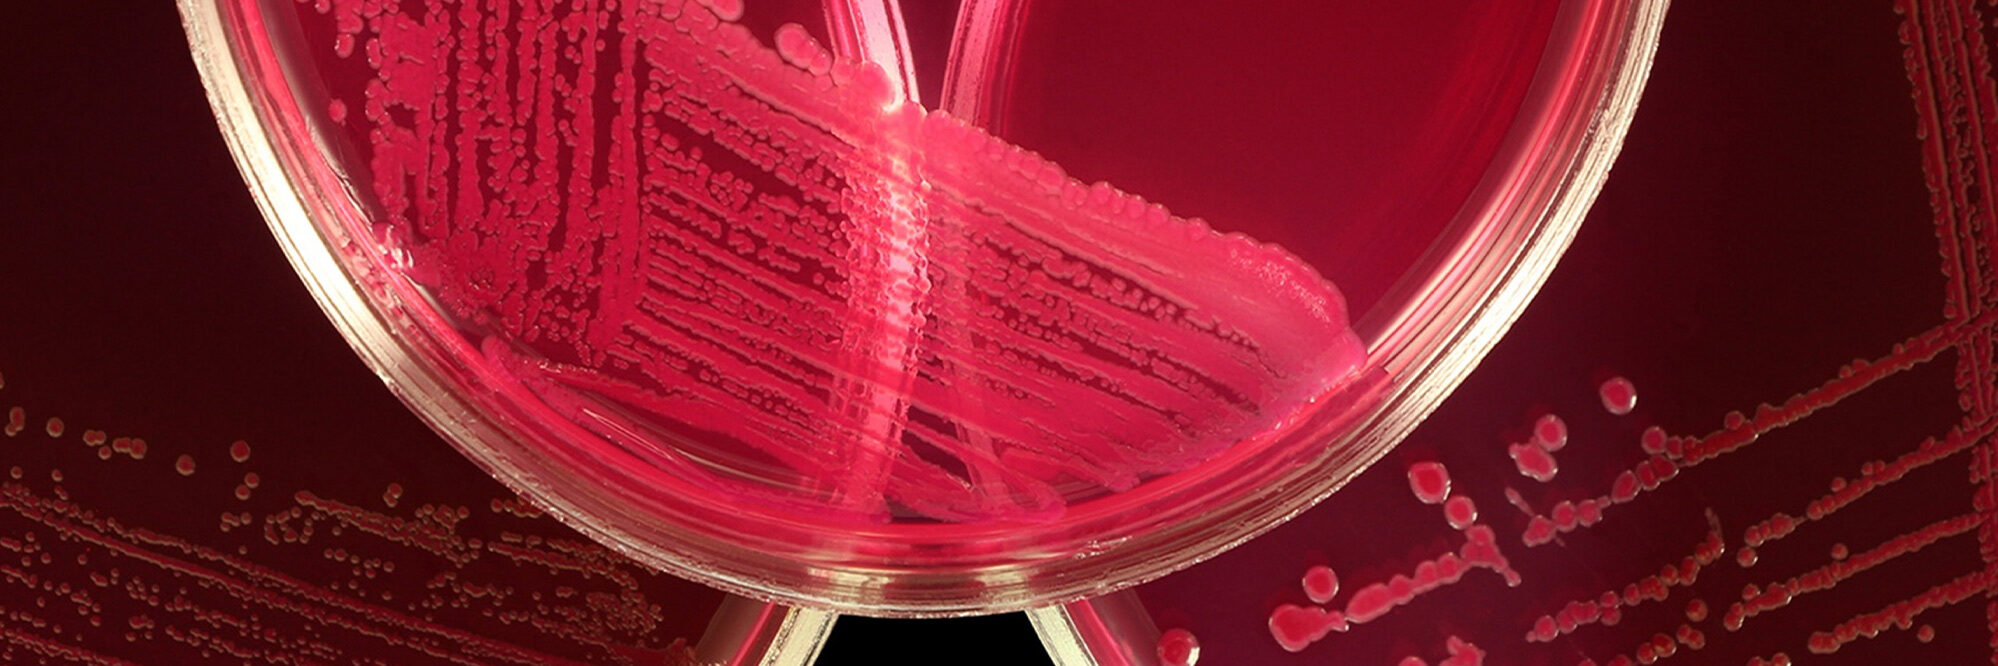
Biomedical and clinical science

Aboriginal and Torres Strait Islander knowledge
Across our research, we collaborate with Aboriginal and Torres Strait Islander Elders and communities to ensure the strategies we develop are culturally appropriate and underpinned by Indigenous knowledge, practice and perspective.

Agriculture and environment
Finding ways to address environmental challenges, conserve biodiversity and secure the future of sustainable, economical and ethical food production.
Biomedical and clinical science
Our scientists are advancing new treatments for major chronic diseases including Alzheimer’s disease, inflammatory disorders, heart disease, traumatic brain injury and cancer.

Business, society and community
Our research is informing business and government, across human rights, housing, economic growth and prosperity nationally and internationally.

Data science, machine learning and AI
Our expertise in data science, machine learning and AI enables unmatched insight and decision making across a vast range of applications, including health sciences, agriculture, business, design, technology and more.

National resilience and security
We work closely with industry and government on a broad range of research projects to help ensure Australia’s resilience and security.

Healthy communities
The Curtin enAble Institute is helping people lead independent and healthier lives in their communities and their homes.

Resources, mining and critical minerals
From exploration and environmental assessment to decommissioning and restoration, Curtin has an exceptional track record of research across the spectrum of resources activities.

Space
We’re engineering and operating some of the world’s most advanced radio astronomy technologies, uncovering the origins of the Solar System and exploring the expanses of space.

Structural engineering and monitoring
Structural degradation and corrosion cost the Australian economy more than $30 billion each year, yet much of the damage to materials can be avoided through efficient monitoring and prevention technologies.

Sustainability and energy transition
We’re developing new materials, new practices and new policies that will reduce our planetary footprint, accelerate the energy transition and improve quality of life for all.